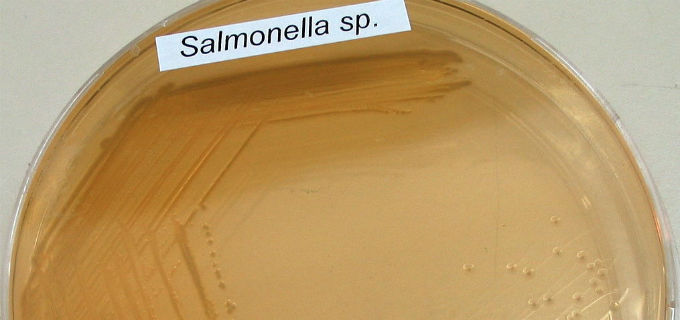

Our website www.isglobal.org (the "Website") uses cookies to collect information on how the Website is used.
A cookie is a file downloaded onto your machine (computer or mobile device) for storing data that may be updated and retrieved by the entity that installed it.
The information collected via cookies may include the date and time you visited the website, the pages you viewed, the time you spent on our website and the websites you visited before and after visiting our site.
We use cookies to facilitate your browsing of our Website, distinguish you from other users, provide you a better use experience and identify problems with our Website. If you provide your consent, we will use cookies to obtain information on your preferences and tailor our Website to your interests.
The purpose of this cookies policy is to provide you with clear and precise information on the cookies used on our Website (the "Cookies Policy"). For more information on the cookies used on our Website, please email your questions to the Data Protection Officer: lopd@isglobal.org.
Type of cookies used on the Website
Our Website uses the cookies described below.
First-party cookies
These cookies are sent to your computer and handled only by us to improve the operation of the Website. Information collected is used to improve the quality of our service and your user experience. These cookies remain in your browser for longer. This allows us to recognise you when you return to the Website and tailor the content offered to your preferences.
Third-party analytics cookies
Interacting with the content of our Website can also cause the installation of third-party cookies (e.g., when you click on social network buttons or watch videos hosted on our Website). Third-party cookies are installed by other domains; not ours. We cannot access the data stored in the cookies of other websites when you browse those websites.
Our Website uses Google Analytics audience measurement system, Facebook, First Party, Twitter, Vimeo, YouTube, Instagram, Issuu and Opinion Stage. These tools allow us to know how users interact with our Website. We use "persistent" cookies. Persistent cookies store data on your terminal that can be accessed and processed during a defined time period by the owner of the cookie. This time period could be anything from a few minutes to several years.
Below is a list of cookies according to the purpose for which the data obtained is processed:
- Technical cookies. These cookies allow you to browse a webpage, platform or application and use the options of the services you find there. For instance, they are used for monitoring web traffic and data communication, identifying the session, providing access to restricted areas, remembering elements in an order, carrying out the purchasing process of an order, performing a request for enrolment or participation in an event, using security elements during browsing, storing content for the playing of audiovisuals, and sharing content via social networks.
- Personalisation cookies. These allow you to access the service and have some general characteristics predefined based on a series of criteria found in your terminal, such as language, browser type with which you are accessing the service, regional configuration from where you are accessing the service, etc.
- Analytics cookies. These cookies allow monitoring and analysing user behaviour on a website. Information collected via this type of cookie is used to measure the activity of websites, applications or platforms and for creating the browsing profiles of users of these sites, applications and platforms. This allows introducing improvements based on the analysis of user usage of the service.
- Advertising cookies. These allow managing, in the most effective manner possible, advertising spaces.
- Behavioural advertising cookies. These cookies store information on user behaviour obtained via the continual monitoring of their browsing habits, which allows creating a specific profile for displaying targeted advertising based on this information.
- External social network cookies. These cookies are used so visitors to websites can interact with the content of social networks (Facebook, YouTube, Twitter, LinkedIn, etc.). They are generated only for the users of these social networks. The conditions of use of these cookies and the information collected is governed by the privacy policy of the social network platform in question.
Along with our server's log files, these cookies tell us the total number of visitors to our Website and which parts of our site are the most popular. Thanks to them, we obtain information that helps us improve browsing and provide a better service to our users and clients.
Visit the following link to Google's website to read about the type of cookies used by Google Analytics and their expiry time.
Consent
By browsing and remaining on our Website, you provide consent for our use of the cookies described for the time periods specified under the conditions of this Cookies Policy.
Disabling and blocking cookies
Cookies are not required for using our Website. You can block and disable cookies by configuring your browser to block the installation of all or some cookies. Most browsers can be set to warn you of the presence of cookies or block them automatically. If you block cookies, you may continue using our Website. However, the use of some of its services may be limited, and your user experience may be diminished.
Withdrawing your consent
If at any time you want to withdraw the consent you gave under this Cookies Policy, delete the cookies stored on your machine (computer or mobile device) via the settings and configuration of your web browser.
For more information on deleting, disabling or blocking cookies, visit this page.
Changing your browser's cookie configuration and settings
Unless you have adjusted your browser's configuration, our system creates cookies when you visit our Website. All web browsers allow changing this configuration.
Click on the links below for how to adjust the cookie configuration of the following browsers:
Internet Explorer:
Changes to the Cookies Policy
We may update the Cookies Policy of our Website from time to time. We recommend that you review this policy each time you visit our Website so that you are adequately informed on how and for what we use cookies. The Cookies Policy was last updated on March 11, 2020.
Contact
For any query, comment or suggestion regarding our Cookies Policy, please email the Data Protection Officer: lopd@isglobal.org.
[Updated on March 11, 2020 · Photo: Christopher Burns / Unsplash]